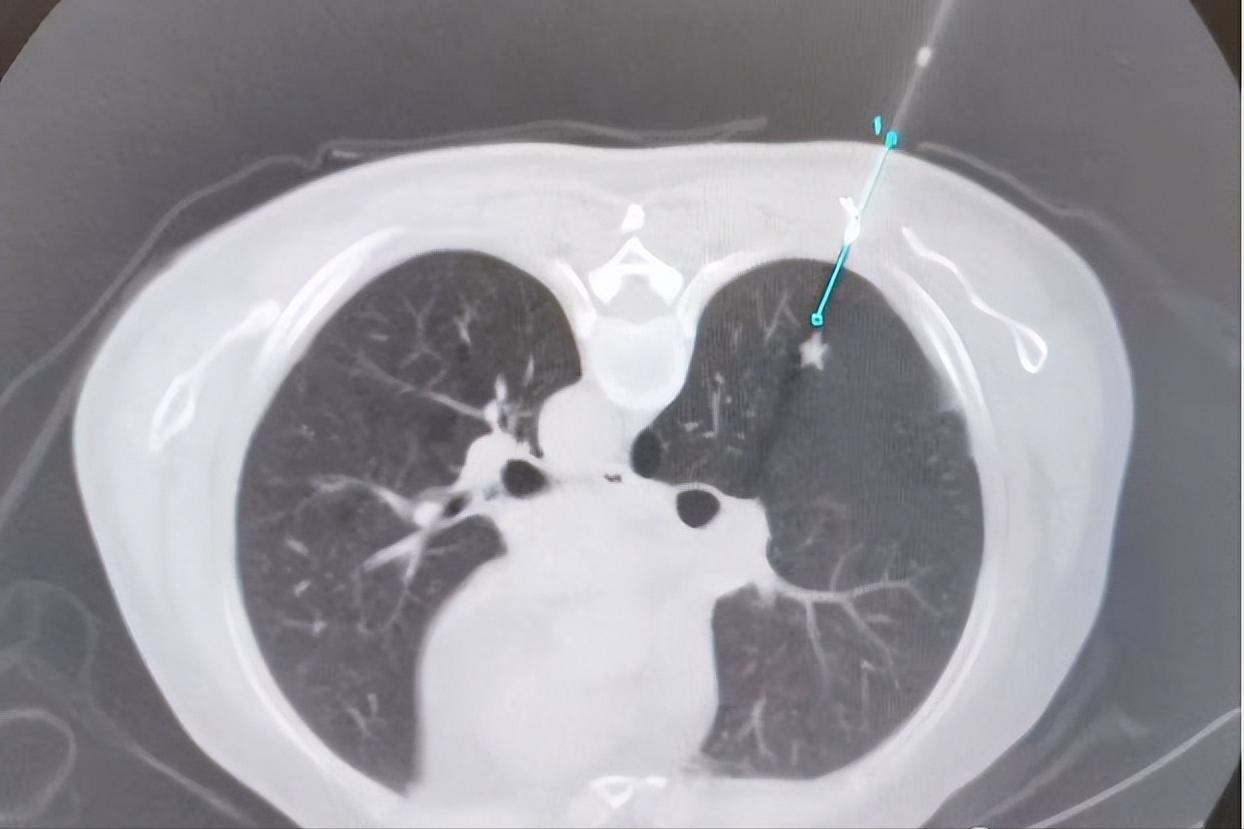
经皮肺活检术,经皮环肺静脉射频消融术名词解释

随着人们健康意识的提高,高分辨率薄层CT的普及,日常生活中,“肺结节”已经成为一个大家耳熟能详的名词。
“肺结节”指影像学表现为直径≤3 cm的局灶性、类圆形、密度增高的实性或亚实性肺部阴影,可为单发或多发,不伴肺不张、肺门淋巴结肿大和胸腔积液。
人们对肺结节有两种不同的态度:有的人不以为然,因为百分之九十以上的肺结节为良性病变;相反,另一部分人对之非常恐惧,因为有一部分肺结节会发展成浸润性肺癌。
其实,对于肺结节,大家既要认真面对,听取专科医师的处置意见,也不必谈之色变。哪怕是需要手术的高危肺结节,也是可以通过微创的方式成功解决肺结节的困扰。
近日,北京市应急总医院呼吸与危重症医学科运用经皮同轴套管肺穿刺活检+微波消融术,成功救治了一名高度考虑恶性病变的肺结节高龄患者,极大地减轻了患者生理和心理上的痛苦。
病情回顾
患者男性, 70岁,因反复自发性气胸,发现右肺结节3天来院。
患者40天前因咳嗽出现了右侧胸部的撕裂样疼痛,后逐渐出现呼吸费力,当地医院查胸部CT见右侧气胸,右肺外压性不张,置入右侧胸腔引流管,半月后气胸好转拔管出院,后反复出现气胸。期间查胸部CT见右肺下叶背段结节,考虑肺癌可能。

入院后完善检查,胸部CT显示右肺下叶背段实性结节,边缘毛刺,形态不规则,高度考虑恶性病变可能。
手术方案
考虑到患者高龄,长期吸烟史,肺大疱,反复自发性气胸,肺功能差,难以行外科手术切除。应急总医院呼吸与危重症医学科主任周云芝带领团队综合分析患者病情,运用当今先进的多技术综合诊疗技术,为该患者制定了“一次性”诊疗方案——经皮同轴套管肺穿刺活检+微波消融术。
一次穿刺即能活检又能消融结节,微创操作,损伤小,减少因多次穿刺引起患者不适及并发症的发生。
手术过程
设计穿刺路径:
穿刺活检后:

消融治疗中:


治疗后安全返回病房:

如何区分肺结节良恶性?
“肺结节”越来越常见,检查出“肺结节”难免使人焦虑、担忧。临床中专业医生是如何区分肺结节的良恶性的呢?
⑴看大小:小于6mm的实性结节或者亚实性结节,恶性概率小于1%。这种6mm以下的结节,占所有结节的90%。结节越小,恶性度就越低,结节越大恶性度就越高。大于3cm的肿块多为恶性肿块。
⑵看形态:分叶征、毛刺征、血管集束征以及胸膜牵拉征多提示恶性结节。边缘光滑多提示良性结节,如平滑肌瘤、乳头状瘤和结核球等。
⑶看密度:肺结节根据密度不同可分为:纯磨玻璃结节、混杂密度结节和实性结节,其恶性程度也随着实性成分增多越来越高。
⑷看危险因素。长期大量吸烟史,年龄≥40岁,肺癌或其他肿瘤家族史,既往有慢阻肺、肺纤维化、肺结核等患者。肿瘤发生的风险较高。
如果发现直径>0.8cm的肺结节,需要根据具体情况,进行非手术活检、手术切除、放化疗、随访等处理。
微创治疗
一种具有创伤小、疗效明确、安全性高、可重复性强、适应人群广等特点的局部热消融术——微波消融(MWA),作为一种精准的微创治疗方式进入了肺结节的治疗视野中。
微波消融(MWA)一般采用915 MHz或2,450 MHz两种频率。在微波电磁场的作用下,肿瘤组织内的水分子、蛋白质分子等极性分子产生极高速振动,造成分子之间的相互碰撞、相互摩擦,在短时间内产生高达60℃-150℃的高温,从而导致细胞凝固性坏死。由于辐射器将微波能集中在一定范围内,故而能有效地辐射到所需靶区。微波消融只会损伤局部设定范围内的细胞而不会破坏周围的组织,消融范围可控。
因此,本次手术方案中一次穿刺操作,既可以取得结节的病理结果,又可以消融结节,使患者在最小的创伤下得到最大的获益。
科室介绍

应急总医院呼吸与危重症医学科是医院的重点科室,集医疗、教学、科研为一体,对门诊病房、支气管镜室、肺功能室统一管理的独立临床科室,2014年率先在北京市开通了呼吸道梗阻“绿色通道”,实行24小时接诊、住院半小时内得到有效治疗。科室在秉承传统的呼吸专业基础上,重点发展呼吸介入诊疗技术,目前处于全国领先水平。
目前开展的呼吸介入治疗技术包括:⑴经气道的技术:硬质镜、氩气刀、二氧化碳冷冻、球囊扩张、激光、低温等离子射频、微波、气道支架置入及取出、放射性粒子植入、局部药物注射、光动力治疗、各类瘘口的封堵等,全面解决患者的气道梗阻及气道瘘问题。⑵经皮穿刺技术:全身各部位的穿刺活检术及实体肿瘤消融术,包括氩氦刀、微波、射频、激光、放射性粒子植入、间质光动力等技术。⑶经血管介入技术:开展了支气管动脉灌注化疗、栓塞及血管内支架技术,应用于肺癌及咯血患者治疗,取得非常好的疗效。